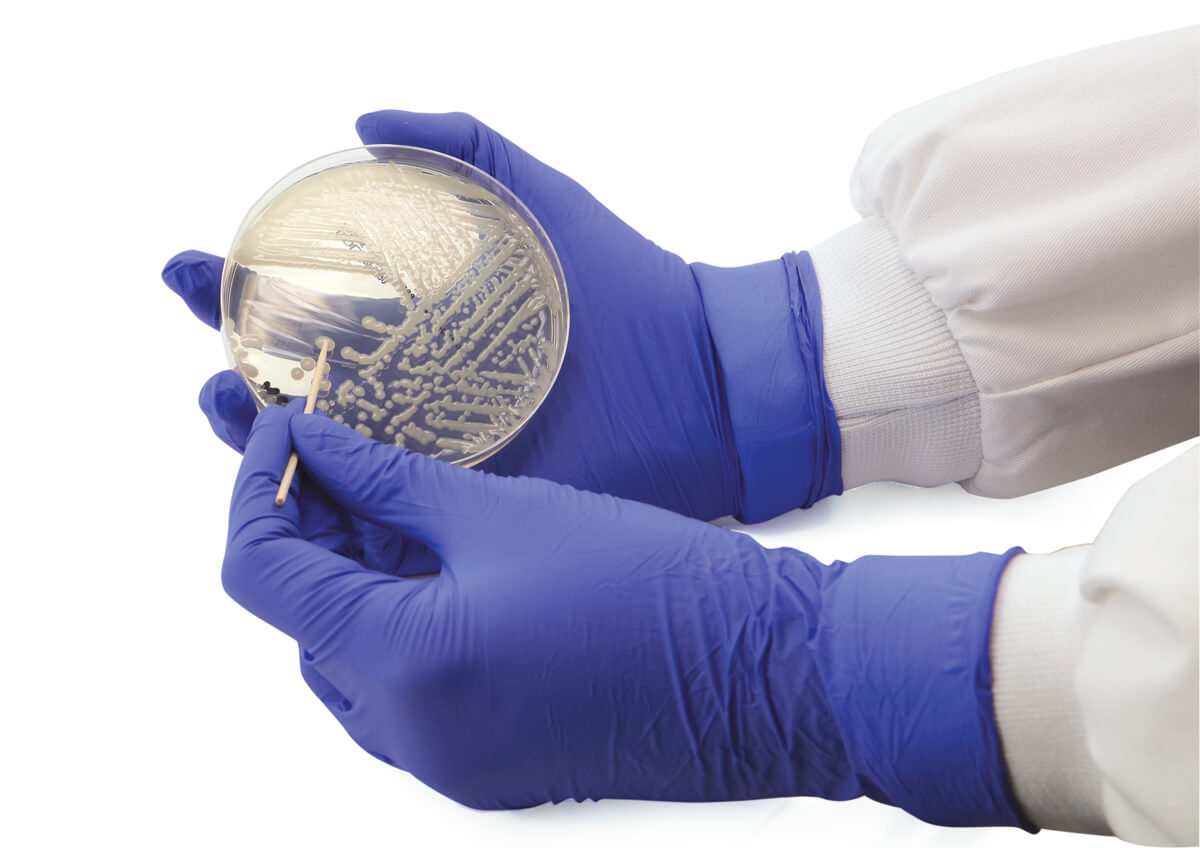
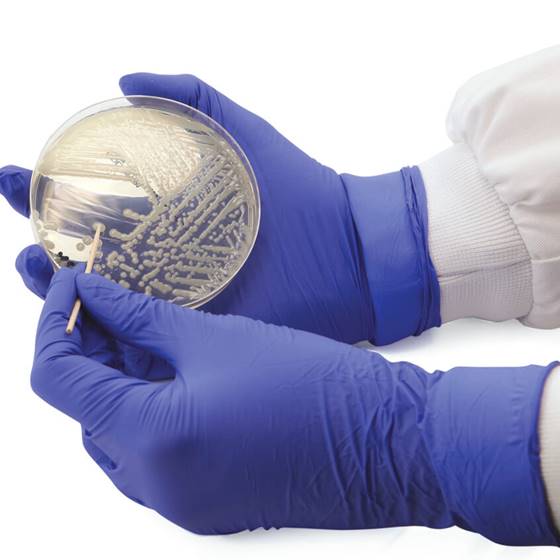

About the product
MAST ISOPLEX® CRE-ART is a loop mediated isothermal amplification kit (LAMP) for the detection of the 7 most common carbapenemase families from bacterial cultures: OXA-48, OXA-23, OXA-24/40, KPC, VIM, NDM and IMP. The ready to use reagents are provided as lyophilised pellets containing all the necessary components for successful amplification.
The assay consists of an 8-tube strip, whereby each of the 7 specific carbapenemase targets occupies its own tube, as does the inhibition control. Extracted DNA is added to each tube in the strip to allow the simultaneous testing of all 7 carbapenemase families. The test offers a rapid turnaround with only 15 minutes of sample preparation (including a quick boil and spin extraction) followed by a 30 minute run time.
MAST ISOPLEX® CRE-ART uses LAMP to provide a rapid solution for the detection and characterisation of carbapenemase-producing organisms (CPOs) making molecular testing accessible to laboratories with limited resource and experience. Early detection of CPOs with CRE-ART will aid appropriate therapeutic decision making in order to improve patient prognosis, prevent further transmission and reduce hospital costs.